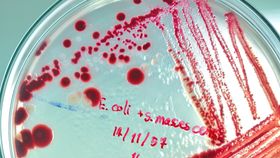

Artificial intelligence (AI) has proved to be a useful ally in the battle against antibiotic resistance. A powerful antibiotic that’s even able to kill superbugs has been discovered thanks to a machine-learning algorithm.
The rest of this article is behind a paywall. Please sign in or subscribe to access the full content.Researchers from MIT used a novel computer algorithm to sift through a vast digital archive of over 100 million chemical compounds and spot those that were able to kill bacteria using different mechanisms from existing drugs.
Reported in the journal Cell, this method highlighted a molecule that appeared to possess some truly remarkable antibiotic properties. The team named the molecule halicin, a hat tip to the sentient AI system “Hal” from Stanley Kubrick’s film 2001: A Space Odyssey.
When tested in mice, halicin was able to effectively treat tuberculosis and drug-resistant Enterobacteriaceae, the family of bacteria that includes E. coli and Salmonella. It also proved extremely effective against Clostridium difficile, a "stomach bug" that often sweeps through hospitals, and another drug-resistant bacterium that can cause infections of the blood, urinary tract, and lungs.
“Our approach revealed this amazing molecule which is arguably one of the more powerful antibiotics that has been discovered,” James Collins, the Termeer Professor of Medical Engineering and Science in MIT’s Institute for Medical Engineering and Science (IMES) and Department of Biological Engineering, said in a statement.
Strangest of all, this potent antibiotic is structurally not like any other antibiotic seen before. If it were up to just humans, it’s very likely this antibiotic would not have been discovered at all because it looks so unusual.
“This groundbreaking work signifies a paradigm shift in antibiotic discovery and indeed in drug discovery more generally,” added Roy Kishony, a professor of biology and computer science at Technion (the Israel Institute of Technology), who was not involved in the study.
Following the success of halicin, the team returned to the database and used the AI algorithm to sniff out more potential candidates. Within just three days, it identified 23 candidates that were structurally dissimilar to existing antibiotics and non-toxic to human cells. Later tests proved at least eight of these molecules had antibacterial properties, and two were particularly powerful.
All of these candidates could turn out to be invaluable tools for tackling superbugs and antibiotic-resistant infections. Due to the overuse of antibiotics, some potentially dangerous bacteria have evolved drug resistance, making them extremely tricky to treat. The Centers for Disease Control and Prevention currently estimate that at least 2.8 million people get an antibiotic-resistant infection each year in the US and more than 35,000 people die from one. This is a trend that’s not going to stop any time soon as more and more bacteria gain resistance to conventional drugs.
Thankfully, as this study shows, AI could help researchers expand our current arsenal of antibiotics and keep this problem at bay.